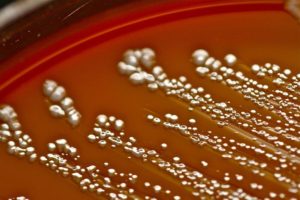

Энтерококк фекальный у мужчин — причины и лечение, профилактика
Природой заложено присутствие в органах человека посторонних микроорганизмов, которые, говоря простым языком, делятся на «полезные» и «вредные». Тут важен баланс. Нельзя сказать, что последние являются чрезвычайно опасными для здоровья.
Напротив, они даже помогают, но до определенного времени, пока не начнется их активное размножение. К таковым относится энтерококк фекальный. Enterococcus faecalis в мазке у мужчин встречается реже, чем у женщин.
По показаниям медицинской статистики данное семейство бактерий «предпочитает» представительниц «слабого пола».
Описание
Одноклеточные частицы имеет овальную форму со слегка заостренным передним краем – «носиком». Локализуется поодиночке или создавая небольшую цепочку. Если пациент здоров, данный вид палочки, наряду с другими микроорганизмами, не вредит, а помогает деятельности пищеварительной системы.
Организм, благодаря защитным силам, контролирует количество таких частиц, не позволяя им увеличивать свои «колонии». Однако при ослаблении иммунитета бактерия трансформируется и уже не является безвредной, напротив, переходит в разряд болезнетворных.
Опасность состоит в том, что выходя из-под контроля, энтерококкус фекалис начинает быстро размножаться и распространяться в других составляющих тела, в первую очередь, в мочевыделительной системе. Более того своей деятельностью микроорганизмы провоцируют возникновение серьезных патологий.
Причины возникновения энтерококка фекального у мужчин
Как уже упоминалось, одним из основных факторов, влекущих увеличение палочки, считается снижение иммунитета. Существую и другие угрожающие причины возникновения, к которым следует отнести:
- инфекционные заболевания (также и венерологические);
- эндокринные сбои;
- авитаминоз;
- пренебрежение гигиеническими правилами;
- несбалансированное питание;
- болезни органов пищеварения;
- микротравмы заднего прохода и головки полового органа.
Кроме того, отмечается ряд случаев, когда заражение enterococcus faecalis происходит еще быстрее. Это наблюдается, если у пациента повышенный уровень сахара, ВИЧ, иные хронические заболевания. Спровоцировать разрастание патогенных титров может длительный прием антибиотиков. В результате антибиотикотерапии гибнут также полезные бактерии, их место занимают патогенные.
Симптомы и признаки
Первоначально увеличение числа вредоносных организмов остается практически незамеченным. Вот это и ухудшает положение, ведь человек даже не подозревает о происходящих изменениях. Однако долго оставаться в «скрытом» виде разрушительная деятельность палочки не может. Появляются симптомы, наглядно демонстрирующие, развитие enterococcus faecalis у мужчин:
- Мутнеет моча, в ней появляются примеси беловато-зеленого цвета;
- Из отверстия пениса выделяется неприятно пахнущая слизь;
- Учащаются позывы сходить в туалет, при этом процесс мочеиспускания вызывает дискомфорт и жжение;
- Опорожнение кишечника болезненное;
- Не проходят ноющие боли внизу живота, яичках, паху;
- Донимает сильный зуд анального и мочеиспускательного отверстия;
- Снижается половое влечение;
- Нарушается эрекция;
- Пациент испытывает слабость, быструю утомляемость.
Если долгое время не предпринимается никаких мер по лечению, наблюдается ухудшение общего самочувствия: озноб, повышение температуры, психоэмоциональные расстройства.
Методы диагностики
При появлении хотя бы 1-2 из перечисленных признаков нужно обратиться к врачу. Далее последует направление на лабораторное обследование. Только таким путем можно диагностировать внутренние нарушения.
Для выявления патологических изменений у мужчин сдаются следующие анализы:
- Общий анализ мочи и крови;
- Тест-соскоб из уретры;
- Кал на бактериологический посев;
- Спермограмма;
- Мазок из заднего прохода.
Виды по локализации
Бактерия enterococcus весьма широко распространена в окружающей среде. Обитает она и в организме теплокровных животных, человека. Всего в природе насчитывается 15 подвидов семейства. Что касается фекального вида микроорганизма, чаще он локализуется во рту, прямой кишке. Если начинается активация его размножения, «расселяется» в другие места.
Энтерококк фекальный у мужчин может быть выявлен в:
- уретре;
- семенниках;
- мочеточнике;
- в простате.
Анализ на Enterococcus Faecalis у мужчин, норма
Общие заборы биологического материала для исследования берутся в лаборатории медицинского учреждения. Если мазки и соскобы, а также кровь с мочой сдаются с помощью специалиста, то сперма собирается самостоятельно. Это необходимо сделать в стерильных условиях методом мастурбации. Для точного определения высевания enterococcus faecalis следует соблюдать правила:
- Приходить в клинику утром, желательно с 8 до 10 часов;
- Половые органы должны быть вымыты, но без применения мыла и других противомикробных средств;
- Не употреблять алкоголь перед обследованием в течение 2 дней;
- Исключить жирную, соленую пищу, газированные напитки;
- За 3-4 дня до сдачи анализа воздержаться от сексуальных контактов;
- Если ведется прием противомикробных препаратов, то до забора биоматериала (в этот же день) их пить нельзя, лучше это сделать после сдачи анализов.
Результаты выдаются, как правило (зависит от клиники) уже на следующий день. По их показателям врач-инфекционист поставит диагноз, имеется ли факт распространения бактериального заражения. Оценка качества спермы позволяет проверить активность сперматозоидов и подтвердить или исключить присутствие простатита, который бывает частым последствием негативной деятельности фекального энтерококка.
Поводом для беспокойства становится повышенный показатель титр. одноклеточных частиц считается нормой:
- В мазке с уретры – до 10 в 5 степени;
- В сперме – до 10 в 3 степени;
- В моче – до 10 в 4 степени;
- В посеве (кала) – от 10 в 5 до 10 в 7 степени;
Изменение показателей в большую сторону (во избежание негативных последствий) требует незамедлительного лечения.
Фекальный энтерококк: общая схема лечения
Стратегия лечебных мероприятий строится на приведение количества бактерий к норме. Учитывая их чрезвычайную живучесть, сделать это бывает довольно непросто.
После прохождения лабораторного обследования выявляются очаги локализации патогенных организмов. Только после этого проводится медикаментозное назначение.
Лечение энтерококка фекального у мужчин производится разными методами, которые подразумевают применение:
- Антибиотиков («Гентамицин», «Цефтриаксон», «Ампициллин»);
- Средств локального воздействия (суппозиториев, бактерицидных растворов, геля);
- БАДов, витаминных препаратов («Простодин», «Прегнавит», «Мульти-Табс», «Виталюкс»).
Принимая антибиотики необходимо помнить, что они влияют на микрофлору, соответственно, следует запастись пребиотиками для ее восстановления.
Точная схема лечения составляется врачом на основании индивидуальных показаний. В наиболее тяжелых случаях назначается физиотерапия. Наряду с этим необходимо соблюдать правильный пищевой рацион.
Различные форумы в Интернете содержат советы по применению народных средств, однако применять их не стоит. Самостоятельно лечить бактериальное заражение небезопасно.
Влияние на потенцию и зачатие
Энтерококк, расселяясь по мочеполовой системе, колонизируется, в большей степени, в предстательной железе и уретре, влечет там вспышку воспаления. Со временем жизнедеятельность патогенных частиц приводит к ослаблению либидо. Дискомфортные ощущения в половых органах отталкивает от близости.
Но еще более серьезная проблема заключается в том, что негативные изменения затрагивают и физиологические способности. Патогенные организмы, попавшие в семенную жидкость, вредят сперматозоидам, которые вначале теряют подвижность, затем вовсе погибают. Таким образом, вопрос стоит уже не только о влиянии на зачатие, но и вовсе о бесплодии у мужчин.
Одним из серьезных последствий заражения энтерококком является простатит. Соответственно, сексуальное здоровье ухудшается, потенция становится слабой. Со временем это приводит к хронической эректильной дисфункции, которую не получится вылечить до конца.
Последствия и осложнения
Запущенное заражение enterococcus faecalis приводит к роковым последствиям. Постепенно развиваются серьезные заболевания и состояния:
- пиелонефрит;
- уретрит;
- эндокардит;
- нарушение центральной нервной системы;
- тазовые, внутрибрюшные инфекции;
- энтерококковый менингит.
Вывод: в случае превышения норм требуется немедленно предпринять меры.
Профилактика
Для защиты от неприятных последствий разрастания бактерий фекального энтерококка необходимо соблюдать ежедневную профилактику.
- Ни в коем случае не забывать о гигиенических правилах. Регулярно принимать водные процедуры, руки должны тщательно мыться после возвращения с улицы, посещения туалета. Следить за чистотой нижнего белья;
- Урегулировать сексуальную жизнь, избегать интимных связей со случайными партнерами, не забывать про средства контрацепции;
- Внимательно относиться к рациону питания, не курить и не злоупотреблять спиртным;
- При наличии хронических заболеваний проводить соответствующее лечение, по максимуму избегая рецидивов. Укреплять иммунитет и регулярно проходить медосмотр.
Полностью «изгнать» enterococcus faecalis из организма не получится. Но можно снизить чрезмерного размножения. ПОМНИТЕ: любое патологическое состояние легче поддается лечению в самом начале развития.
И если начали беспокоить первые, даже незначительные, изменения в самочувствии, следует тут же обратиться к специалисту.
Само по себе ничего «не рассосется», а вот безвозвратно надорвать мужское здоровье игнорированием симптомов вполне реально.
Энтерококки в мазке и моче — что это такое
Многочисленных представителей микрофлоры человека можно разделить на три условные группы: патогенные, непатогенные и условно-патогенные микроорганизмы. К последним и относится enterococcus faecalis.Важно знать, что это за бактерия, почему наличие большого количества enterococcus faecalis в мазке у мужчин является поводом для беспокойства и как с ней бороться.
Краткое описание бактерии
Особенностью условно-патогенной микрофлоры вообще, и энтерококка, в частности, является стойкость к воздействию антибиотиков, а также к воздействию высоких и низких температур. В связи с этим необходимо знать, что такое энтерококк, чтобы понимать, как с ним бороться.
Общая характеристика
Enterococcus spp. (энтерококки) — это группа бактерий, относящихся к подклассу лактобактерий. Наиболее известным представителем является энтерококк faecalis (он же энтерококк фекальный). В норме эта бактерия является частью микрофлоры рта и кишечника (помогает пищеварению), в малых количествах может присутствовать на слизистой оболочке мочеполовой системы.
Численность этих бактерий держится на одном уровне благодаря работе иммунитета. Однако, при сбое в работе иммунной системы либо под действием каких-либо факторов внешней среды, численность бактерий может возрасти, и они могут вызвать ряд патологических процессов в мочеполовой системе.
Чаще всего энтерококк фекальный у мужчин обнаруживается в мазке из уретры. В самом факте обнаружения энтерококка нет ничего страшного, обращать внимание следует на количество бактерий.
Причины заражения
Как уже было сказано выше, энтерококк фекалис обитает в каждом организме и при нормальной численности не представляет опасности. Однако, при неблагоприятном стечении обстоятельств численность энтерококка резко увеличивается, и он начинает питаться клетками органа, на котором паразитирует.
Чаще всего энтерококком поражаются органы мочеполовой системы, но болезнь может развиваться и в органах желудочно-кишечного тракта.
Причинами заболевания энтерококком являются:
- Незащищённый половой контакт (в особенности чередование анального и генитального секса).
- Неправильная гигиена после туалета либо отсутствие гигиены вообще.
- Развитие вирусной инфекции (в том числе ВИЧ).
- Гибель других представителей микрофлоры (под действием антибиотиков).
- Передача от матери к новорождённому ребёнку.
- Трансплантация органов (крайне редко).
Кроме того, здоровый человек может являться носителем энтерококка, но при этом не болеть и не испытывать неудобств. Тем не менее, в таком случае сохраняется опасность заражения партнёра.
Первые симптомы энтерококка у мужчин
При попадании в организм энтерококк имеет свойство в течение долгого времени вести себя незаметно и никак не проявляться. Поэтому диагностика на самых ранних этапах подчас затруднительна. При появлении первых симптомов заражения рекомендуется обратиться к врачу незамедлительно.
При подозрении на заболевание энтерококком у мужчин необходимо обратить внимание на следующие симптомы:
- Боли в области полового члена. Она может носить острый, ноющий, жгучий, ноющий характер, отличается высокой интенсивностью. Кроме того, болевые ощущения часто отдают в пах, промежность, яички и даже поясницу. Возможен дискомфорт при мочеиспускании и движении.
- Ложные позывы к мочеиспусканию либо, наоборот, недержание.
- Дискомфорт во время дефекации (при натуживании).
- Проблемы с эрекцией (эректильная дисфункция).
- Проблемы с эякуляцией (может вообще не происходить).
- Потемнение мочи с появлением хлопьев белка.
- Выделения из канала уретры. Обладают резким, гнилостным запахом и зеленоватым оттенком.
- Проблемы с непосредственно мочеиспусканием.
- Спёртый оргазм.
- Повышение температуры до 37−37,5 градусов.
- Общая слабость и сонливость.
При игнорировании симптомов есть риск запустить болезнь, что может вызвать следующие заболевания:
- Простатит.
- Уретрит.
- Сепсис.
- Гнойные воспаления половых органов.
- Бесплодие.
- Импотенция.
При развитии инфекции возможно как проявление всех признаков, так и лишь некоторых, поэтому необходимо быть особенно внимательным ко всем отклонениям в работе мочеполовой системы.
Диагностика заболевания
Появление любого из этих симптомов должно заставить человека обратиться к урологу для проведения диагностики. Она включает в себя следующий комплекс мер:
- Осмотр специалистом.
- Общий анализ мочи и крови.
- ПЦР (полимеразная цепная реакция). Помогает выявить энтерококк даже при отсутствии симптомов.
- Бактериологический посев. Исследование культуры с определением уровня чувствительности к антибиотикам. Также возможно использование метода при отсутствии симптомов.
- Ультразвуковое исследование (УЗИ).
- Магнитно-резонансная томография (МРТ).
- Компьютерная томография (КТ).
- Уретроскопия.
- Микроскопия мазков.
Наиболее эффективной мерой признаётся бактериологический посев мазка. После забора образцов из уретры они высаживаются на культуральную среду и выращиваются в течение 3−4 суток, по прошествии которых проводится выявление и подсчёт микробов.
При исследовании содержания enterococcus faecalis норма у мужчин признаётся равной 10 в 5 степени или менее. В этом случае назначение лечения не имеет смысла. При превышении этой цифры считается, что содержание enterococcus faecalis в мазке у мужчин не соответствует норме, и можно говорить о риске развития патологии.
Методы лечения
Ввиду устойчивости энтерококка к воздействию значительного количества антибиотиков, а также способности к длительному бессимптомному существованию вопрос своевременного лечения и профилактики остро стоит перед каждым ответственным мужчиной. Целью лечебных мероприятий при энтерококковой инфекции является устранение вызвавших инфекцию бактерий и восстановление нормальной микрофлоры. Поэтому применяется комплекс лекарств:
- Антибиотики. Ввиду высокой устойчивости к антибиотикам у enterococcus faecalis, применяются специальные препараты. Наилучший эффект оказывают следующие медикаменты: рифаксимин, таваник, доксициклин. Данные препараты обладают высокой эффективностью и безопасны для организма. Курс лечения составляет одну неделю при приёме по одной таблетке два раза в сутки.
- Противомикробные препараты. Чаще всего применяется «Метронидазол», который уничтожает микробы в желудочно-кишечном тракте.
- Иммуномодулирующие препараты. Применяются для укрепления иммунитета в комплексе с общей терапией.
- Витамины.
- Физиотерапия.
- Лечебная физкультура.
Помимо этого, возможно применение раствора содержащего бактериофаг. Бактериофаг-это вирус, уничтожающий определённый тип микроорганизмов. При применении раствора содержащего бактериофаг можно гарантировать сохранность полезной микрофлоры при уничтожении энтерококка.
При энтерококковой инфекции рекомендуется делать ингаляции раствора бактериофага в уретру, а также промывать им крайнюю плоть и головку полового члена. Курс лечения от недели до десяти суток.
Профилактические меры
В целях избежания заражения энтерококком рекомендуется соблюдение следующих профилактических мер:
- Всегда соблюдать правила личной гигиены.
- При любом виде секса использовать презерватив.
- При посещении общественных туалетов избегать прямого контакта с сантехникой.
- Всегда мыть руки после посещения туалета.
Помните! Ответственное отношение к себе и другим — залог счастливого будущего.
Enterococcus faecium: описание, причины и лечение
- Enterococcus faecium (энтерококки фекальные) являются грамположительными бактериями и относятся семейству энтерококковых бацилл.
- Данные бактерии способны провоцировать развитие инфекционных процессов в различных органах, как правило, это органы урогенитальной системы.
- Одним из важнейших методов диагностики подобного заражения является лабораторное исследование образцов мочи на присутствие в них энтерококков.
Фекальный энтерококк
Enterococcus faecium, или энтерококк фекальный, представляет собой условно-патогенную бактерию. Это значит, что при его присутствии в организме не обязательно начинается болезнь. В норме фекальные энтерококки взаимодействуют с человеческим организмом симбиотически. Данная бактерия – неотъемлемая часть кишечной микрофлоры, играющая важную роль в процессе пищеварения.
Однако бывают ситуации, когда микроорганизмы начинают неконтролируемо размножаться и приобретают характер болезнетворных. Чаще всего это случается на фоне общего ослабления организма.
Если человек здоров, рост и размножение энтерококков сдерживают иммунная система и полезные бактерии. При ослабевании контролирующих факторов начинается аномальный рост количества микроорганизмов.
Некоторые из них покидают кишечную среду и переселяются в органы мочевыделительной и других систем.
В норме энтерококки фэциум питаются, поглощая продукты жизнедеятельности человека, однако, оказавшись не в кишечнике, они начинают питаться клетками организма, в результате чего возникает процесс воспаления, развиваются разнообразные патологии.
Кроме того, на фоне заражения энтерококками существует риск присоединения дополнительной инфекции – заражения грибком или вирусом, так как энтерококк ослабляют защитные свойства клеток, из которых состоит слизистая.
Что провоцирует размножение?
Аномальное размножение энтерококков может начаться в следующих ситуациях:
- Длительное использование антибиотических медикаментов. Данные препараты способны уничтожать многие бактерии, полезные для организма. Вместе с тем, энтерококки воздействию не подвергаются, так как имеют высокую резистентность. Наряду с этим антибиотики вызывают снижение иммунитета. Сочетание таких факторов приводит к началу бесконтрольного размножения энтерококков.
- СПИД.
- Применение иммунодепрессантов.
- Ослабление организма вследствие перенесенной болезни, стрессов, при беременности, от плохого питания, алкогольной зависимости.
Заражение из внешней среды
Также возможно заражение энтерококками из внешней среды. Такое случается обычно при проведении медицинских процедур, которые затрагивают внутренние органы. Также заражение может произойти в процессе хирургической операции, если плохо соблюдались условия стерильности.
Симптомы
В начале заражения никакого ухудшения самочувствия у человека не возникает. Но анализы на этом этапе уже могут показать присутствие бактерий. Со временем, по мере прогрессирования инфекции развивается следующая симптоматика:
- У мужчин снижается потенция. У женщин отмечаются боли при половом акте.
- Общее недомогание, температура.
- Воспаление уретры.
- Болезненность в мочевом пузыре.
- Покраснение, воспаление гениталий.
- Болезненность при мочеиспускании, частые позывы.
Диагностика предполагает прежде всего лабораторное исследование образцов мочи на enterococcus faecium. Проводится общее исследование урины.
У женщин фекальные энтерококки могут обнаруживаться также в гинекологическом мазке.
Патологии, провоцируемые фекальными энтерококками
Чаще всего фекальные энтерококки провоцируют развитие патологий в урогенитальной системе, таких как:
- Пиелонефрит.
- Цистит.
- Уретрит.
Кроме того, возможно инфицирование микроорганизмами половых органов, в результате может развиваться:
- Воспаление простаты.
- Аднексит.
- Вульвит.
- Вагинит.
Энтерококки также могут стать причиной возникновения пищевого отравления, энтерита, дисбактериоза, гастрита.
В редких случаях наблюдается поражение мозга, сердца и развитие, соответственно, менингита, эндокардита. При отсутствии адекватной терапии в условиях сниженного иммунитете существует риск развития сепсиса.
Особенности развития болезни у детей, женщин, мужчин
Наиболее подверженной заражению категорией пациентов являются беременные женщины. Связано это в первую очередь с застойными явлениями в мочевом пузыре, общей ослабленностью организма из-за вынашивания ребенка.
При беременности обнаружение enterococcus faecium в мазке является наиболее опасным, так как могут усложнять ее течение.
В некоторых случаях инфицирование способно спровоцировать преждевременные роды, заражение плода, патологии в его развитии.
Долго протекающие, недолеченные заболевания инфекционной природы женской мочеполовой системы приводят к воспалительным процессам в органах малого таза.
Enterococcus faecalis (энтерококк фекальный) в мазке у женщин
Бактерия enterococcus faecalis, обнаруженная в мазке, она же энтерококк фекальный или кишечный, это микроорганизм, который обычно живет в кишечнике человека и является условно-патогенным.
То есть может вызвать заболевание, но только при определенных условиях — если попадет в благоприятную для него среду (в рот, вагину, мочевыделительную систему) при сниженном иммунитете (характерно для беременности).
Провоцирует цистит, аэробный вагинит, пиелонефрит и другие болезни.
Гинеколог диагностирует данного возбудителя по результатам бакпосева на флору. Это анализ, который иногда берут у будущих мам в плановом порядке без наличия каких-либо жалоб, а также в случае плохого общего мазка, если обнаружено слишком много лейкоцитов.
Иногда мазок на флору или чистоту из влагалища берут одновременно с бактериальным посевом. Это если у женщины уже имеются симптомы гинекологического заболевания, инфекции, например, необычные выделения, зуд.
Таким образом, получится назначить правильное лечение в более скорые сроки, ведь посев выполняется не один день.
Нужно подождать, пока в отделяемом из влагалища и цервикального канала, взятом на анализ, размножились микроорганизмы.
Симптомы энтерококка faecalis у женщин
Фекальный энтерококк находят в мазках у 25% женщин, и чаще это норма. Далеко не всегда он дает какую-либо симптоматику. Если количество микроорганизма не велико, возможно, он даже попал из прямой кишки в мазок из-за неправильного его взятия у здоровой женщины, никаких признаков бактерия не дает.
Если же развивается аэробный вагинит — воспаление влагалища, вызванное резким ростом аэробной микрофлоры (включая Enterococcus faecalis), то есть микроорганизмов, которым для развития жизненно необходим кислород, то выраженность признаков заболевания будет зависеть от его степени. Подробнее о стадиях развития аэробного вагинита вы можете судить по таблице.
Для наглядности в цифрах:
- 10 во 2 степени или 10 в 3 степени — умеренный рост, вероятно, энтерококк попал во влагалище из прямой кишки случайно;
- 10*4 кое/мл, 105, 106, 10 в 7-й степени— обильный рост.
Если воспаление есть, то будут следующие его проявления.
- Боль во время полового акта, так называемая диспареуния.
- Обильные желтые выделения без неприятного запаха (в отличие от бактериального вагиноза, вызываемого анаэробными микроорганизмами, когда есть запах тухлой рыбы).
- Отечность и покраснение преддверия и стенок влагалища.
- Зуд и жжение в вагине. Иногда женщины жалуются, что щипят половые губы.
Перечисленные сигналы организма становятся особенно яркими после менструации.
Периодически симптомы становятся менее выраженными, женщина чувствует улучшение, но потом вновь следует обострение.
Причины появления кишечного энтерококка во влагалище и пути заражения
Из кишечника микроорганизмы попадают во влагалище при анально-вагинальных контактах, обычных половых актах; из-за близости анального отверстия и входа во влагалище, неправильного подмывания и ношения стрингов, плохого соблюдения личной гигиены и т. д.
Особенно часто аэробный вагинит возникает у девочек и у женщин в период менопаузы. Проблема заключается в низком уровне эстрогена, маленьком количестве или полном отсутствии лактобактерий.
Улучшить микрофлору влагалища, заселить ее полезными микроорганизмами женщинам при климаксе поможет заместительная гормональная терапия, в том числе использование препаратов местного действия — «Овестина».
Кстати, именно с низким уровнем эстрогена связана другая гинекологическая патология — атрофический кольпит.
При половом акте может передаваться от одного партнера к другому, как любой другой условно-патогенный возбудитель, но в незначительных количествах.
Лечение фекального энтерококка у женщин
Если симптомов заболевания нет, лечения не требуется. Если есть, то назначают антибиотики внутрь и местно антибактериальный или антисептический препарат.
Есть мнение, что обязательно нужно лечиться, если энтерококк фекальный выявлен при взятии мазка из цервикального канала. Якобы наблюдать можно, только если он находится исключительно во влагалище. Но микрофлора влагалища и цервикального канала практически идентичная.
А в матку болезнетворные микроорганизмы просто так не попадут.
Помешает слизистая пробка (она образуется не только у беременных женщин!), менструация (во время нее эндометрий отторгается со всеми болезнетворными бактериями), постоянное физиологическое обновление плоского эпителия и бели — вагинальные выделения также «чистят» слизистую.
Из антибиотиков предпочтение обычно отдают следующим:
- «Гентамицин;
- «Сизомицин»;
- «Амикацин»;
- «Тобрамицин»;
- «Нетилмицин»;
- «Левофлоксацин»;
- «Линезолид»;
- «Амоксиклав»;
- «Амоксициллин»;
- «Левофлоксацин»;
- «Цефотаксим»;
- «Рифаксимин»;
- «Нифурател»;
- «Цефтриаксон»;
- «Ципрофлоксацин».
Пефлоксацин, ломефлоксацин, офлоксацин, норфлоксацин слабо активны. Более точно определить эффективное лекарство помогает результат бакпосева. В результате этого анализа вы найдете к какому антибиотику бактерия резистентна (невосприимчива) и чувствительна.
Из местных препаратов бороться с enterococcus faecalis помогают:
- Тержинан;
- Полижинакс;
- Гексикон.
| Схема лечения №1 | «Гентамицин» 2 раза в день в течение 5 суток + свечи «Тержинан» по 1 перед сном — 10 дней. После возможно использовать препараты для нормализации микрофлоры кишечника и влагалища. «Бифидумбактерин» внутрь и «Ацилакт» вагинально. Но это не обязательно. |
| Схема лечения №2 | 1 свеча «Вагинорм С». На следующий день антибиотики «Ципрофлоксацин» в дозировке 500 мг 2 раза в день в течение недели. Параллельно с этим свечи «Тержинан» по 1 штуке в течение 10 дней. После окончания курса антибиотиков — еще 5 дней «Вагинорм С» и затем для восстановления микрофлоры влагалище «Экофемин» в течение 10 дней. |
| Схема лечения №3 | «Ампициллин» в дозировке 0,25 по 2 таблетки 4 раза в день в течение одной недели. На ночь 1 суппозиторий «Гексикон» вагинально. |
| Схема лечения №4 | «Ципринол» по 500 мг 2 раза в день. На 3 и 10 день лечения антибиотиком — «Микомакс» 150 мг. Со второго дня лечения антибиотиками внутрь, вагинально комбинированный антибиотик «Полижинакс» в течение 12 дней. После этого, восстановить микрофлору влагалища свечами «Вагинорм-С» (6 дней). |
Некоторые врачи прибегают к альтернативному лечению — повышению иммунитета, чтобы организм смог сам бороться с кишечным микроорганизмом. Или назначают бактериофаг для кишечника. Сторонники доказательной медицины к таким назначениям относятся скептически. «Рифаксимин», «Виферон» и подобные препараты не обладают доказанной эффективностью и безопасностью.
Если есть проявления грибковой инфекции (молочницы) — назначают «Макмирор».
Без антибиотиков не обойтись беременным, так как для них последствия этого воспалительного процесса могут быть особенно тяжелыми.
Чем опасен аэробный вагинит, последствия болезни
Возможно развитие тяжелого эндокольпита — воспалительно-дистрофического поражения стенок влагалища и шейки матки. Это часто провоцирует следующие осложнения при беременности:
- преждевременный разрыв околоплодного пузыря с отхождением амниотической жидкости;
- хориоамнионит;
- преждевременные роды;
- внутриутробная задержка развития плода;
- рождение ребенка с низким весом.
Аэробный вагинит усугубляется воспалительными заболеваниями малого таза:
- эндометрит;
- сальпингит;
- оофорит;
- тубоовариальный абсцесс;
- тазовый перитонит.
Симптомы заболеваний женских репродуктивных органов:
- сильная боль во время менструации и в другие фазы цикла; боль отдает в поясницу, крестец, промежность;
- ощущение жара и распирания в промежности;
- болезненность при половом акте и снижение полового влечения;
- бесплодие;
- слизистые, серые бели;
- повышение температуры тела;
- боли при мочеиспускании.
Осложнения заболеваний репродуктивных органов:
- рубцевание, спайки в маточных трубах;
- внематочная беременность;
- регулярные боли в тазу;
- тубо-овариальный абсцесс;
- пельвиоперитонит.
Сопутствующая enterococcus faecalis условно-патогенная флора и термины
Данные научные определения вы можете прочесть в результатах анализов. Пугаться этих микроорганизмов не стоит. Все они условно-патогенные. Не всегда вызывают болезнь. Относятся к аэробным, то есть способны провоцировать аэробный вагинит.
Подробнее о кокках в мазке читайте в этом материале.
Enterococcus faecalis — что это такое? Симптомы и лечение
Энтерококки – большое семейство анаэробов и аэробов. То есть эти бактерии способны жить как в среде свободного кислорода, так и в кислотной. Энтерококки очень распространены. Среди бактерий есть безопасные для человека штаммы, которые применяют в пищевой и лекарственной промышленности. Однако определенные их виды опасны для здоровья людей. Особенно они «любят» женский пол.
Ранее энтерококки входили в семейство стрептококков класса Д, однако недавно им отвели отдельную классификацию. Сегодня известно около 15 видов изученных бактерий этой группы, однако ученые до сих пор не исследовали и не классифицировали до конца некоторые из них.
Повышение энтерококков в анализах
В анализах врачи обращают внимание на enterococcus faecalis. Что это такое? Это бактерия, которая относится к условно-патогенным и при превышении ее нормы способна вызывать патологические состояния. Сегодня мы рассмотрим энтерококк фекальный более подробно и выясним, как его лечить, если он обнаружен в мазке у женщин.
Enterococcus faecalis в норме находится в ротовой полости и в кишечнике (преимущественно тонкая и толстая кишка) человека. Превышение его нормы встречается как у мужчин, так и у женщин, однако наиболее часто он разрастается у будущих мам, чей организм перестраивается, и потому особенно уязвим.
Также наблюдается рост enterococcus faecalis у женщин при злоупотреблении антибиотиками. Врачи считают, что пациенты часто заражаются и при лечении в условиях стационара, так как энтерококк фекальный очень устойчив во внешней среде.
Более того, многие антибиотики не оказывают на него никакого губительного воздействия.
Часто у женщин при взятии мазка на анализы обнаруживается повышенное количество enterococcus faecalis.
Что это такое и чем чревато? Относясь к условно-патогенным, они в любом случае находятся в организме, но при увеличении их количества эти бактерии могут вызывать воспаления, если попадают в среду, несвойственную для них – к примеру, мочевыводящие пути или почки, куда они проникают из прямой кишки.
В этом случае может наблюдаться бессимптомная бактериурия (повышенное содержание микроорганизма в моче). Во влагалище они могут присутствовать в незначительном количестве. Если же их больше, обычно по причине недостаточной гигиены, они вызывают воспаления.
Установлено, что и в моче, и в мазке энтерококки обычно обнаруживаются одновременно либо, после жизнедеятельности во влагалище, они начинают «обживать» и мочеполовые пути, вызывая такие заболевания, как цистит или даже пиелонефрит.
Другие причины обнаружения enterococcus faecalis в мазке у женщин – это незащищенные половые контакты и использование чужих средств гигиены или вещей больного.
Установлено, что при снижении иммунитета энтерококк, который до этого присутствовал в организме в весьма скромных количествах, начинает разрастаться.
Обычно снижение иммунитета происходит на фоне приема антибиотиков или других средств.
Женщин, у которых нашли enterococcus faecalis в мазке, беспокоят:
- Болезненное жжение при мочеиспускании, частые позывы к нему.
- Снижение либидо; женщины жалуются на практически полное отсутствие оргазма.
- Неприятно пахнущие, обильные выделения из влагалища различной консистенции (творожистые или слизистые).
- Сильные и часто повторяющиеся боли в спине.
- Боль в низу живота и в паховой области.
Также женщины страдают от общего плохого самочувствия. Наблюдается снижение работоспособности и быстрая утомляемость.
Энтерококк фекальный при беременности
Обнаруженный у беременных enterococcus faecalis — что это такое? У женщин в положении эта бактерия встречается в 5 раз чаще, так как их гормональный фон снижается наряду с иммунитетом.
Наличие энтерококка фекального в моче говорит о том, что в мочевыводящих путях есть воспаление, которое требует немедленного вмешательства.
Беременным следует очень тщательно подбирать антибактериальную терапию.
В первые месяцы после родов грудничок находится под тщательным присмотром врача. У ребенка также может быть обнаружено увеличенное содержание энтерококка в кале. Молодая мать может заразить ребенка и через грудное молоко.
Как лечат фекальный энтерококк?
Если обнаружен enterococcus faecalis в мазке у женщин, существует определенная схема лечения, которая включает следующие средства.
Основная терапия энтероккока фекального, в особенности учитывая его резистентность ко многим видам антибиотиков, заключается в использовании бактериофагов (буквально «уничтожителей бактерий», которые относятся к вирусам).
Они встраиваются в клетку бактерии и убивают ее. Бактериофаги превосходят антибиотики меньшим количеством побочных эффектов и безопасностью для кишечника.
Их зачастую назначают детям и тем, кто имеет противопоказания к приему более агрессивных средств.
Взрослым женщинам, которые не находятся в положении, назначают антибактериальные препараты – «Цефтриаксон», «Ампициллин», «Гентамицин». Энтерококки чувствительны к этим видам лекарств.
Дополнительная терапия
В качестве дополнительной терапии показаны витаминно-минеральные комплексы и средства для местного применения – свечи, влагалищные таблетки. Женщинам назначают спринцевание и физиотерапию. Спринцеваться рекомендуется растворами с добавлением в воду перекиси водорода и соды. Они снижают неприятную симптоматику (в частности, выделения) и нормализуют микрофлору влагалища.
Основная цель лечения – снизить содержание энтерококков до нормы. Если их количество не превышает ее, то они безопасны для организма и не вызывают никаких неприятных симптомов.
Сегодня мы рассмотрели enterococcus faecalis — что это такое, какие симптомы вызывает, и как устраняется эта бактерия.
Enterococcus Faecalis (фекальный энтерококк) в мазке у женщин: норма и отклонения, причины и лечение
Бактерия под названием фекальный энтерококк относится к грамположительным микробам и является условно-патогенной микрофлорой.
В небольших количествах эта бактерия не вызывает проблем со здоровьем, но в случае активного размножения способна вызывать серьезные болезни мочеполовой системы.
Уровень опасности
К фекальному энтерококку более восприимчивы женщины, у которых бактерия вызывает воспалительные процессы в мочеполовых органах.
Сам микроорганизм в определенных количествах обитает в кишечнике, особенно в тонкой кишке.
Выделяется с каловыми массами, которые содержат до 90 % этой бактерии, может долго сохраняться в воздухе.
При неблагоприятных факторах — от неправильного питания до несоблюдения элементарных правил личной гигиены — микроорганизм начинает активно размножаться, вытесняя нормальную микрофлору.
Попадая в женские половые органы, уретру, он вызывает патологии вплоть до развития пиелонефрита, уретрита, воспаления яичников и матки.
При несвоевременном обнаружении патологии могут прогрессировать, переходя в хронические формы, с трудом поддающиеся лечению.
Методы выявления и норма
Как обнаружить Enterococcus Faecalis в мазке у женщин, сколько их должно быть в норме?
Фекальный энтерококк можно обнаружить путем взятия мазка из влагалища. Забор материала осуществляется врачом-гинекологом, далее направляется в лабораторию для исследования под микроскопом.
По результатам анализа можно судить о том, на сколько превышено содержание условно-патогенной бактерии.
Если наличие бактерии превышает порог в 10-15%, воспалительный процесс есть. Концентрация в мазке более 30% говорит о сильно выраженной патологии, требующей адекватного лечения.
Причины обнаружения
Причины, по которым фекальный энтерококк может попасть в женские половые органы, немногочисленны.
Самый распространенный фактор, провоцирующий развитие энтерококковой инфекции — несоблюдение правил личной гигиены:
- нерегулярное мытье наружных половых органов;
- использование чужих полотенец, белья, бритв;
- несвоевременная замена гигиенических прокладок и тампонов.
Передается бактерия и половым путем, через незащищенные контакты, поэтому женщины, не использующие барьерные средства контрацепции, не имеющие постоянного партнера, могут заразиться от мужчины.
Микроорганизм начинает активироваться в организме тех женщин, которые перенесли курсы антибиотикотерапии — в ослабленном организме энтерококк развивается активнее, чем у совершенно здорового человека с сильной иммунной системой.
Симптомы развивающейся болезни
Фекальный энтерококк может поражать как половые органы, так и мочевую систему, при серьезном течении — почки и мочевой пузырь. С момента активного размножения микроорганизма у женщин начинают появляться тревожные симптомы.
При поражении фекальным энтерококком больные чаще отмечают:
- неприятные боли в нижней части живота ноющего характера, усиливающиеся при мочеиспускании;
- боли в спине, возникающие периодически, по характеру — интенсивные, давящие.
Выделения отмечаются практически у всех женщин.
При поражении влагалища и половых путей выделения обильные, по цвету — от сероватых до светло-коричневых, запах — неприятный. Выделения сопровождаются жжением, дискомфортом во влагалище.
Меняется характер мочеиспускания — оно становится учащенным, скудным. Могут возникать внезапные резкие позывы, процесс выделения мочи становится болезненным.
Ухудшается общее состояние больных:
- постоянная усталость, слабость;
- сонливость даже при наличии полноценного сна;
- снижение полового влечения.
Лечение
При обнаружении в анализах превышения допустимой концентрации фекального энтерококка — в мазках из влагалища, моче, кале — лечение важно начать сразу, так как микроорганизм быстро размножается, губительно влияя на весь организм.
Основные группы препаратов
Адекватная терапия против фекального энтерококка включает:
- антимикробные препараты, антибиотики;
- препараты для наружного использования;
- медикаменты для укрепления организма и иммунитета.
Антибиотики позволяют быстро остановить развитие инфекционно-воспалительного процесса. Важно подобрать антибиотик, к которому микроорганизм будет чувствителен.
Самые популярные и действенные антибиотики:
- Цефтриаксон;
- Гентамицин;
- Доксициклин;
- Ципрофлоксацин.
Назначают их чаще внутримышечно, в дозах, рассчитанных по весу, возрасту, тяжести болезни. Длительность курса — 7-10 дней, не дольше.
В последнее время в терапии против энтерококковой инфекции часто назначают бактериофаги — специальные препараты в жидкой форме, которые губительно влияют на условно-патогенные бактерии, вызывая минимум побочных эффектов.
Средства для наружного применения действуют местно, оказывая противомикробный и противовоспалительный эффект. К ним относятся вагинальные свечи, таблетки, гели.
Хорошо зарекомендовали себя:
- Тержинан — вагинальные таблетки;
- Полижинакс — свечи;
- Гексикон — свечи.
Препараты для укрепления иммунной системы тоже важны — ослабленный организм не может полностью подавлять рост условно-патогенной флоры.
Для повышения защитных сил организма в комплексной терапии назначают:
- Виферон — в форме свечей;
- Генферон — в виде свечей;
- поливитаминные комплексы — Витрум, Элевит, Компливит, Алфавит.
Курс приема — не менее месяца, после него делают перерыв 14-30 дней, и прием витаминов и иммуномодуляторов повторяют.
Народные средства
Народная медицина предполагает лечить фекальный энтерококк путем спринцеваний настоями трав с противомикробным эффектом — это аир, шалфей, кровохлебка, ромашка, мать-и-мачеха. Благодаря таким процедурам можно снять неприятные ощущения в половых путях — зуд, жжение, выделения.
Популярный народный рецепт из смеси меда и прополиса помогает укрепить защитные силы организма, приостановить рост патогенной флоры в кишечнике.
Для приготовления смеси надо смешать пополам свежий мед и прополис, выдержать около 2-х суток и принимать по чайной ложке три раза в сутки.
Народные методы лучше применять по разрешению врача в комплексе с основным лечением. Такие методы помогают симптоматически, облегчая общее состояние.
Терапия для партнера
Мужчины подтверждены заражению энтерококковой инфекцией.
В мужском организме микроорганизм поражает кишечник и мочеполовую систему, приводя к развитию:
- уретрита;
- пиелонефрита;
- простатита;
- импотенции.
Лечение партнера включает антимикробные препараты, антибиотикотерапию и средства, укрепляющие иммунитет. После лечения сдаются контрольные анализы.
Заболевание при беременности
При обнаружении в моче или мазке из влагалища у беременных фекального энтерококка в завышенной концентрации лечение начинают сразу. Подобная проблема у женщин в положении — не редкость.
Последствия несвоевременного лечения могут быть нешуточными:
- преждевременные роды;
- рождение ребенка с низкой массой тела;
- плацентарная недостаточность;
- ранее излитие околоплодных вод, задолго до родов;
- внутриутробное инфицирование ребенка.
Лечение беременных должно быть щадящим, чтобы плод не пострадал.
Обычно гинекологи назначают препараты для местного применения — Полижинакс или Тержинан во влагалище, Виферон для активизации иммунитета и пробиотики для приема внутрь — Линекс, Хилак-форте.
После проведенного курса необходимо провести контрольное обследование, чтобы установить, достигнута ли цель терапии.